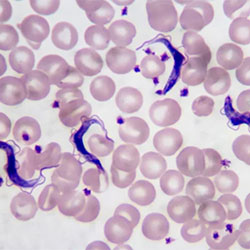

By Ethan Covey
A case of human African trypanosomiasis (HAT), also known as sleeping sickness, was confirmed in a U.S. resident who traveled to Zimbabwe during the summer of 2024, according to a recent report (MMWR Morb Mortal Wkly Rep 2025;74[9]:158-159).
The disease is considered to be endemic in sub-Saharan Africa.
“This report highlights the ongoing risk of acquiring rhodesiense HAT while traveling to endemic areas, particularly in the Zambezi Valley,” said Elizabeth Wendt, MD, MPH, an Epidemic Intelligence Service officer with the CDC’s Division of Parasitic Diseases and Malaria.
The 57-year-old traveler was evaluated at a U.S. hospital in August 2024 with symptoms of fever and a well-demarcated, ulcerated lesion on the left thigh. This came approximately two weeks after potential exposure to Trypanosoma brucei rhodesiense parasites, which are transmitted by the bite of the tsetse fly. Testing confirmed HAT.
While the individual quickly progressed to multisystem organ failure, he eventually recovered and was discharged with mild renal dysfunction.
The prompt diagnosis and treatment likely saved the individual’s life, as early treatment is essential in order to prevent death. “Rhodesiense HAT should be considered in sick returning travelers from endemic regions. The consequences of missing a diagnosis of rhodesiense HAT are serious and can be deadly,” Dr. Wendt said.
In addition to this U.S. case, the WHO identified three additional cases of HAT in people who traveled to the same region. These are the first cases of HAT associated with travel to the Zambezi Valley since 2019.
“The identification of four cases within a short time shows that transmission remains active in this region despite ongoing elimination efforts,” Dr. Wendt said. “These findings reinforce the need for awareness among travelers going to endemic areas to prevent tsetse fly bites.”
While rhodesiense HAT is targeted for elimination as a public health problem, questions exist regarding how to reach elimination targets in remote areas in Africa, Dr. Wendt said. These include whether better diagnostic tools can be developed to identify cases in low-incidence settings, how surveillance and response efforts can be improved in endemic countries, and what role the changing environment plays in tsetse fly ecology.
Pharmacologic developments also may soon help with the treatment of HAT.
“Fexinidazole is a new medication that has been studied in Africa and has received FDA approval for use in the U.S.,” Dr. Wendt said. “Other possible medications for treatment are currently in development.”
Ongoing study will hopefully address lingering questions regarding the use of fexinidazole, such as what the relapse rate is following treatment, how fexinidazole should be dosed in obese patients, and whether fexinidazole administration through a nasogastric tube is equivalent to oral administration.
Dr. Wendt reported no relevant financial disclosures.



